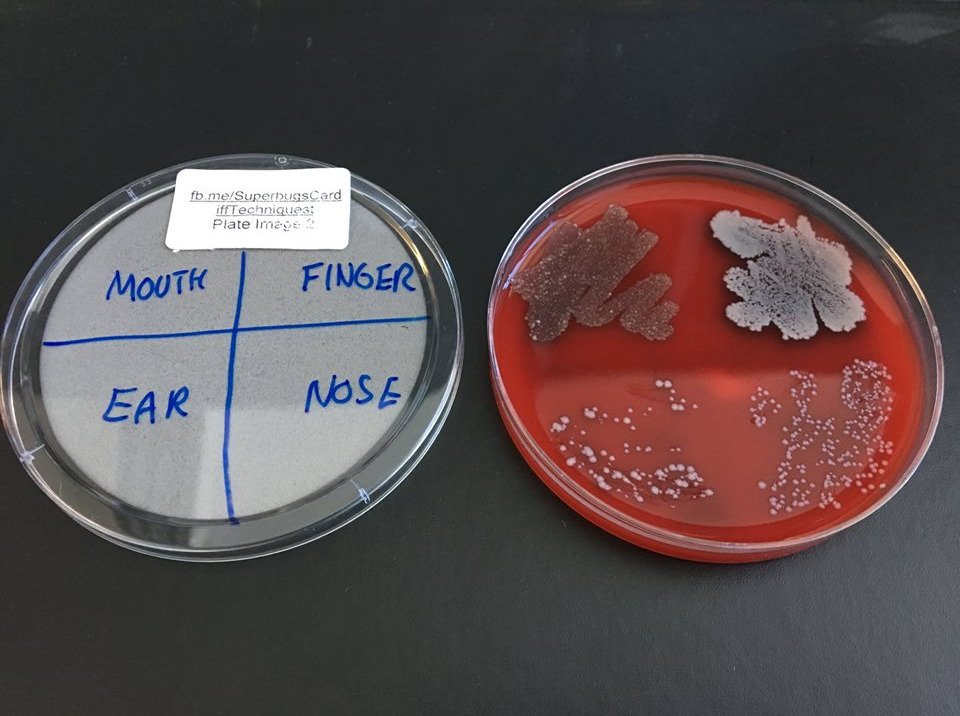
CUSystemsImmu's tweet image. Meet the bugs that are normally invisible but live in your mouth, ear and nose and on your hands or in your armpit - in most cases without causing any harm!

Find here the photos of your bugs from the #CUsuperbugs event on 28 June 2018:
facebook.com/pg/SuperbugsCa…

#wfoi @Techniquest

Lloyd Williams
@technilloyd
Content manager at Techniquest tasked with expanding the science capital and bringing ideas to life to inform and inspire people of all ages.
You might like
It's #charitytuesday today, so there's no better content for my first #tweet other than to mention @Techniquest an amazing charity in the heart of @CardiffBayLife which I'm now proud to be a part of! HELLO CARDIFF I'm your new #communityengagementofficer
From Friday 3rd to Saturday 11th August, Techniquest will be open until 7pm, so you’ve got even more time to play with the exhibits! 🙌

To celebrate the first International Day of LGBTQ+ People in STEM, we’re taking part in a rainbow science show with science centres and museums around the world! 🌈 🌍 #rainbowscience #LGBTSTEMDay
Meet the bugs that are normally invisible but live in your mouth, ear and nose and on your hands or in your armpit - in most cases without causing any harm! Find here the photos of your bugs from the #CUsuperbugs event on 28 June 2018: facebook.com/pg/SuperbugsCa… #wfoi @Techniquest
I recently did quite a big bit of research about how theatres can diversify audiences from a class point of view. You can read a summary of this in the Stage article below or have a look at the (much longer) report here: cloreleadership.org/userfiles/docu…
It’s world microbiome day! Arguably the most important field of biology in the 21st century. worldmicrobiomeday.com
Did you know that as well as being a beloved family attraction, we're also a charity? Support our mission to inspire the next generation of scientists. bit.ly/2oGsGB9

📝 NEW BLOG: Our Content Manager @technilloyd weighs up the pros and cons of using QR code and NFC technology to enhance our exhibits. techniquest.org/blog/scan-tap-…
techniquest.org
Scan or tap, opening doors to more information • Techniquest
Our Content Manager weighs up the pros and cons of using QR code and NFC technology to enhance Techniquest’s exhibits.
We teamed up with @EmoryUniversity for what is likely the first study of bacteria communities on airplanes. Here's what swabs of tray tables, belt buckles, and lavatory door handles determined... ⬇️ ✈️
Before you watch the Caps and Knights play in tonight's #StanleyCup finals, brush up on some hockey-related science courtesy of @ACSChemClubs: ow.ly/TJ4H30kiHIF #ALLCAPS #VegasBorn
teachchemistry.org
Themes | AACT
AACT is a professional community by and for K–12 teachers of chemistry
United States Trends
- 1. #TerrorismProvocation N/A
- 2. Good Tuesday N/A
- 3. FINALLY DID IT N/A
- 4. Davos N/A
- 5. Macron N/A
- 6. #tuesdayvibe N/A
- 7. JUST ANNOUNCED N/A
- 8. The Jito N/A
- 9. #CatForCashEP1 N/A
- 10. Deloitte N/A
- 11. Taco Tuesday N/A
- 12. #WWEUnreal N/A
- 13. The ONDO N/A
- 14. Phillips N/A
- 15. Memories in Orbit N/A
- 16. #KidnappedPresident N/A
- 17. Scott Jennings N/A
- 18. Saleh N/A
- 19. Diego Garcia N/A
- 20. Weston Wilson N/A
You might like
Something went wrong.
Something went wrong.


































































































